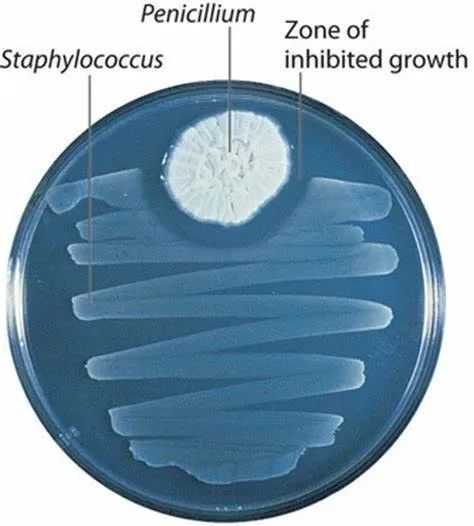
青霉素的注意事项有哪些,青霉素能治什么病害

在中国人的就医用药印象中,一定少不了头孢和青霉素两个大名鼎鼎的抗生素。大大小小的感冒发烧,以及身体各个部位的感染都常常使用到这类抗生素进行治疗。
抗生素作为一种抗病原体类物质,一般具有良好的抗感染作用,可以有效降低细菌感染和传染类疾病的病死率。

青霉素就是一种经典抗生素,随着科学技术的不断发展和进步,抗菌素不断更新换代,然而青霉素从发明到现在药效不减,临床上仍被医生广泛使用。
那么青霉素究竟是如何杀菌的呢?它对细菌和人体细胞又会产生什么样的作用呢?
青霉素的来历
1928年,英国科学家弗莱明在实验研究中意外地发现了自己所培养的葡萄球菌被一团团青绿色霉菌菌落所侵蚀消灭。
葡萄球菌属的微生物常常可以产生一些致病性代谢物,例如血浆凝固酶、溶血素、杀白细胞素、肠毒素等,是一类对人体有健康威胁的微生物。
而培养皿中出现了可以杀死葡萄球菌的霉菌,意味着这种霉菌可能产出了某种可以杀菌的物质,可惜以当时的科学技术,弗莱明并无法确定这种物质究竟是什么,也无法将其以高纯度的形式提取出来。
但是他细心地将这些具有杀菌能力的霉菌一代又一代地培养了起来。
细菌无法在青霉周围生长 S:葡萄球菌,P:青霉菌 Zone:葡萄球菌无法生长的区域
1939年,弗莱明将他悉心培养的菌种提供给英国病理学家弗洛里和生物化学家钱恩,他们开始接手寻找这种可以杀菌的物质。
经过一次次提纯实验后,他们给8只小鼠注射了致死剂量的致病链球菌,然后给其中的4只用提纯物质治疗。几个小时后,仅有经过提纯物治疗的小鼠还健康地活着。
无疑,这种提纯物质正是霉菌可以杀死致病菌的原因,这种人类历史上最重要的抗生素——青霉素,经过十余年的研究终于被人们所认识了。

青霉素分子式
之后的鉴定表明,弗莱明发现的霉菌为点青霉菌(Penicillium notatum),一开始青霉素在国内的称呼便是直接由其英文名Penicillin音译的,即我们常听到的“盘尼西林”。
此后一系列临床实验证实了青霉素对链球菌、白喉杆菌等多种细菌感染均具有良好的疗效。
青霉素的作用方式
那么青霉素究竟是如何杀菌的呢?它除了杀灭葡萄球菌细菌,能不能杀灭其他的细菌呢? 它的杀菌机理到底如何?
青霉素是一类广谱抗生素,也就是说对于许多细菌例如肺炎球菌、淋球菌及链球菌等都有杀灭作用,这也与它的作用机理有关系。
青霉素属于β-内酰胺类抗生素,它可以破坏细菌细胞壁中的N-乙酰胞壁酸和N-乙酰氨基葡糖之间的β-1,4糖苷键。
细胞壁是细菌最外层的屏障,它就像一堵围墙一样保护着细菌,而β-1,4糖苷键就像是搭砌这堵墙的水泥,没有了水泥的联合,挪起来的砖块会轻易坍塌,使细胞壁由不溶性黏多糖分解成可溶性糖肽,导致细胞壁破裂,细菌也就死亡了。

β-1,4糖苷键(红色)是无分支多糖细胞壁形成的连接点
同时,由于β-内酰胺类抗生素作用于细菌的细胞壁,而人类细胞只有细胞膜没有细胞壁,因此青霉素对人类细胞基本没有伤害
但是β-内酰胺类抗生素的作用机制是一个多步骤而复杂的问题,因此对其杀菌机制仍是目前的研究热点。
可惜的是,病毒也没有细胞壁,它只有蛋白质外壳与内部的核酸,所以无法被青霉素杀掉。
因此青霉素对病毒性感染,例如对病毒性感冒等束手无策,因此青霉素并非包治百病的神药。
青霉素使用的注意事项
青霉素毒副作用很小,但需要注意的是过敏症状与耐药性的产生。
青霉素一定要经过皮试才可使用。从药物学角度来说,青霉素是一种半抗原,进入人体后与组织蛋白质结合而成为全抗原,刺激机体产生特异性抗体,存在于体内。
而过敏反应则是由抗原、抗体相互作用而引起,当过敏体质的人遇到相应抗原进入机体后,会产生大量抗体,发生过敏反应。在药物过敏中,青霉素过敏的案例最为常见,这也与其使用人数基数大有关。

青霉素使用前需做皮试
抗生素的不合理使用可以引起许多危害,除了过敏等不良反应等外,最主要的就是细菌抗药性的产生。
在经历了青霉素洗礼、已经奄奄一息的细菌在增殖过程中往往会产生各种变异,在溶菌酶的作用下这些细菌索性脱去了细胞壁,摇身一变进入了一种叫做“L-form”的形态,导致青霉素靠破坏细胞壁杀菌的方法失效了,这会引起许多感染复发。
这些变异出的细菌里,难免就会有一些具有抗药性,但由于所占数量不多,它们对人几乎没有影响。
细菌被抗生素杀灭的过程,相当于一场“优胜劣汰”的选择,不具有抗药性的细菌被杀灭,而一些具有抗药潜力的细菌可能得以存活,经过不断地增殖,这些少数群体越来越多,渐渐地在数量占了优势,成为了这些细菌中的主导力量。
随着同种抗生素一次次地使用,细菌也一代代地被人为筛选着,抗药特性更是一代强于一代,使抗生素的杀菌效果减弱,甚至使这种抗生素失效。滥用抗生素会加速上述这种人为选择的过程,使得细菌很快具有抗药性。
其实,当下的人类正在承受着滥用青霉素的后果,上世纪50年代,一个病人每次注射青霉素只需20万个单位,而到90年代需80~100万个单位才能达到相同的疗效。
不过,我们也没必要过度担心,平时生病时尽量避免使用抗生素,如果病情严重不得不使用时,严格按照医嘱使用即可。
从1928年青霉素第一次出现在人们的视野中,慢慢地,青霉素的使用已遍及全世界,尤其是在二战期间,拯救了千百万肺炎、脑膜炎、脓肿、败血症患者的生命。
由于这一造福人类的杰出贡献,弗莱明、钱恩、弗洛里共同获得了1945年诺贝尔医学和生理学奖。
虽然现代医学的进步也发掘了越来越多的抗生素与其他的治疗手段,但作为经典款的抗生素,青霉素依然没有淡出人们的视野。